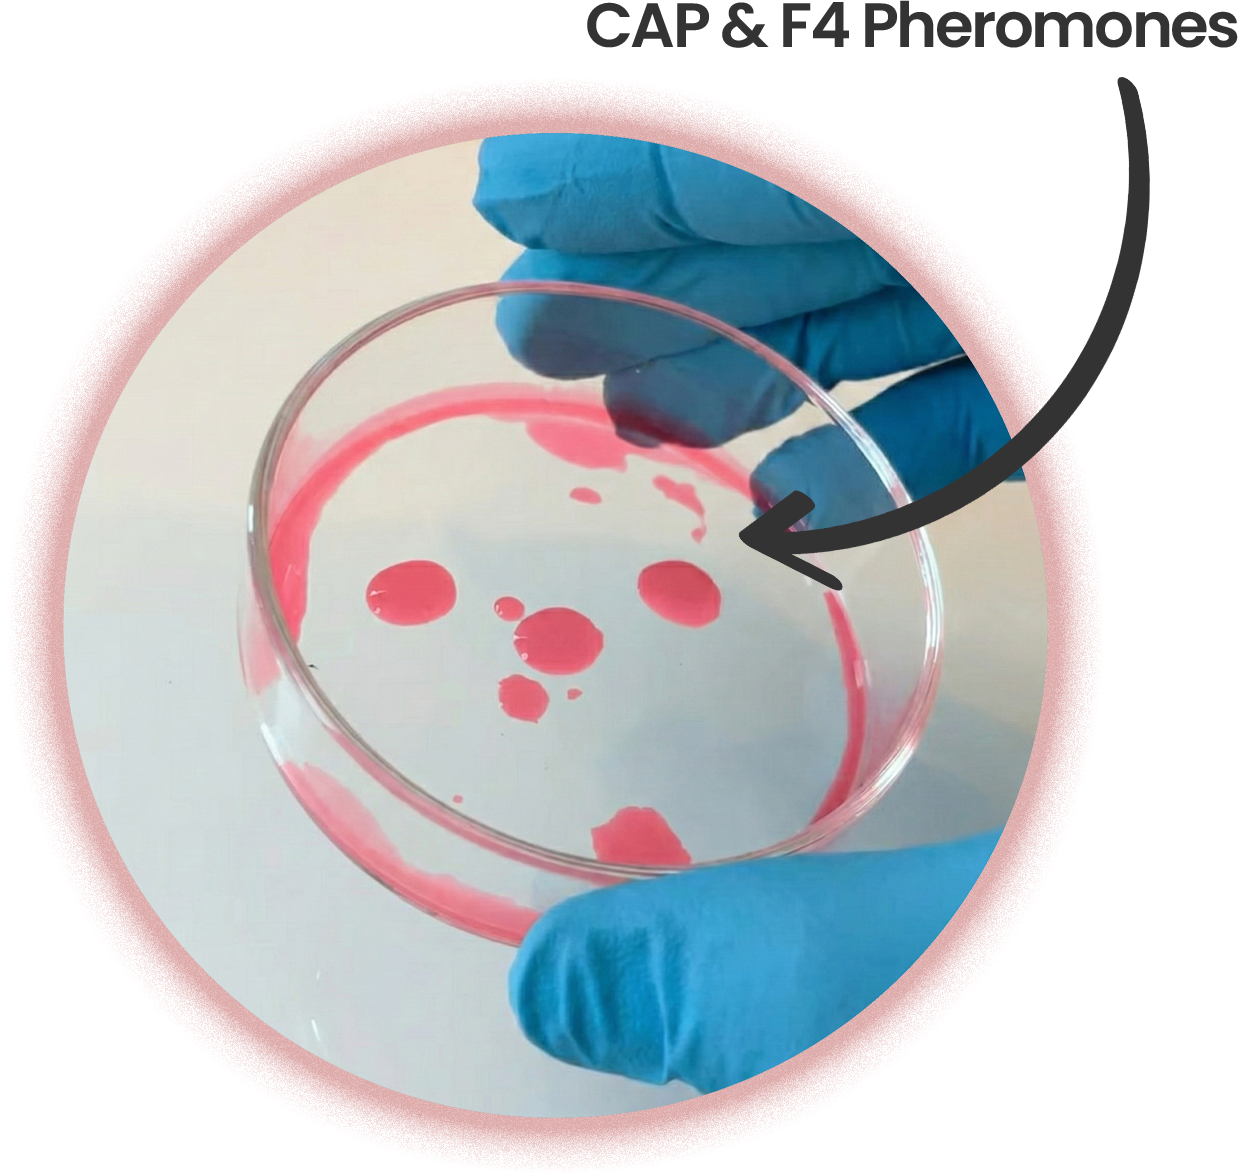

4.9/5 from 1.323 reviews
NEW
CatCalm Gentle
The world’s first pheromone beads for cats
Stops aggressive behavior in 3 days
Creates calmness and relaxation
#1 vet-recommended solution
Trusted by 100,000+ cat parents
90-day money-back guarantee

Klinisch bestätigt

Klinisch bestätigt

Klinisch bestätigt

Klinisch bestätigt
Most Popular + FREE Shipping + 1 FREE
Best Price + Best Results + FREE Shipping + 2 FREE
Most Popular + FREE Shipping + 1 FREE
Best Price + Best Results + FREE Shipping + 2 FREE
*For optimal results, we recommend regular use for 3 to 6 months.


CatCalm Essence Spray For SAME-DAY Results
Spray 3 times daily on your cat's favorite spots. Targets the places where your cat spends the most time. Noticeable improvement in just 24 hours!
69,13 zł
105,51 zł
Add

CatCalm Essence Spray For SAME-DAY Results
Spray 3 times daily on your cats’ favorite spots. Noticeable improvement in just 24 hours!
69,13 zł
105,51 zł
Add
As seen on





No Effect On
Humans & Other Pets

Vet
Approved

Drug Free

Clinically
Proven

No Side
Effects

For All Ages
Designed To Stop Aggressions in 3 Days
CatCalm Gentle contains a high dosage of F4 and CAP pheromones. The precise formula of these two signals addresses the root cause and underlying problem that leads to aggressive behavior towards humans. This is not a one-size-fits-all approach, but it is specifically designed to solve that one problem.
Unlike diffusers, CatCalm Gentle uses gel bead technology to release the pheromones at room temperature, without any heat that would destroy the pheromone molecules before they even reach your cat. Place it freely around your home at your cat's favorite spots.

How It Works
Cats are not naturally aggressive toward the people they live with. Even solitary hunters in the wild know the difference between a friend and a threat. So when your cat repeatedly scratches or bites you, something fundamental is missing.
What most owners don’t realize is that aggression toward humans is almost never just territorial. A cat can accept its home as its territory and still share that space peacefully—unless something deeper is wrong.
Standard pheromone products rely only on F3—the “this is my territory” signal released when cats rub their cheeks on objects. Using F3 alone can even worsen aggression because it reinforces ownership without building trust. It’s like unlocking the wrong lock.
True aggression toward humans usually arises when two things happen at once: the cat never properly learned to feel part of a social group, and it does not see the humans around it as friends.
CatCalm Gentle opens both locks at the same time. It combines CAP—the mother pheromone that instantly creates a sense of group belonging—with F4, the friendship pheromone cats naturally release when they rub their face on someone they trust and like.
Together, CAP and F4 send one clear message: this is our group, and the humans here are friends. CatCalm Gentle turns “What are you doing in my space?” into “You’re one of us”—and the aggression simply stops.

No Effect On
Humans & Other Pets

Vet
Approved

Drug Free

Clinically
Proven

No Side
Effects

For All Ages

No Effect On
Humans & Other Pets

Vet
Approved

Drug Free

Clinically
Proven

No Side
Effects

For All Ages
Designed To Stop Aggressions in 3 Days
CatCalm Gentle contains a high dosage of F4 and CAP pheromones. The precise formula of these two signals addresses the root cause and underlying problem that leads to aggressive behavior towards humans. This is not a one-size-fits-all approach, but it is specifically designed to solve that one problem.
Unlike diffusers, CatCalm Gentle uses gel bead technology to release the pheromones at room temperature, without any heat that would destroy the pheromone molecules before they even reach your cat. Place it freely around your home at your cat's favorite spots.

How It Works
Cats are not naturally aggressive toward the people they live with. Even solitary hunters in the wild know the difference between a friend and a threat. So when your cat repeatedly scratches or bites you, something fundamental is missing.
What most owners don’t realize is that aggression toward humans is almost never just territorial. A cat can accept its home as its territory and still share that space peacefully—unless something deeper is wrong.
Standard pheromone products rely only on F3—the “this is my territory” signal released when cats rub their cheeks on objects. Using F3 alone can even worsen aggression because it reinforces ownership without building trust. It’s like unlocking the wrong lock.
True aggression toward humans usually arises when two things happen at once: the cat never properly learned to feel part of a social group, and it does not see the humans around it as friends.



CatCalm Gentle opens both locks at the same time. It combines CAP—the mother pheromone that instantly creates a sense of group belonging—with F4, the friendship pheromone cats naturally release when they rub their face on someone they trust and like.
Together, CAP and F4 send one clear message: this is our group, and the humans here are friends. CatCalm Gentle turns “What are you doing in my space?” into “You’re one of us”—and the aggression simply stops.
CatCalm Pure
vs. Diffusers


Place it anywhere your cats spend time


Effectiveness
100%
~40%
Safe for cats with asthma


Clean. No oily stains on the wall.


Odorless


Non-Flammable


Specifically formulated to stop aggressive behavior


Guaranteed Effectiveness


CatCalm Pure vs. Diffusers


Place it anywhere your cats spend time


Effectiveness
100%
~40%
Safe for cats with asthma


Clean. No oily stains on the wall.


Odorless


Non-Flammable


Specifically formulated to stop aggressive behavior


Guaranteed Effectiveness


How To Use It
Remove the seal and place the jar where your cat spends the most time. Make sure all rooms where your cat spends time are covered.
The pheromone release is not visible, and humans can't smell it. The gel beads will shrink over time.

*Illustration - Pheromones are not visible.
How To Use It

Remove the seal and place the jar where your cat spends the most time. Make sure all rooms where your cat spends time are covered. The pheromone release is not visible, and humans can't smell it. The gel beads will shrink over time.
What happens
when you use CatCalm Pure?

Day 1
As soon as you place CatCalm Gentle in your home, the room becomes saturated with pheromones. Your cat might approach the jar to investigate and smell it. From day one, the pheromones start doing their thing.

Day 3
The most dramatic change happens now: the aggressive behavior almost stops entirely. Your cat might not be your cuddle buddy yet, but it's clearly getting better day by day.

Week 2
The aggressions are gone. It was days ago your cat attacked you the last time. you can pet them without risking scratches. They come to you to rub their face against your leg. The sign of friendship.

After 1 Month
Bites and scratches are history. You finally have a peaceful and gentle relationship to your cat.
"Is This Right For Me & My Cat?"

This is right for you, if...

Your cat attacks you unprovoked or when you try to pet them

You arms and legs are covered in cratch and bite marks

You’ve tried other products without success

You want a natural, drug-free solution

You’re looking for something easy and safe

You want a peaceful relationship with your cat
"Is This Right
For Me & My Cat?"

This is right for you, if...

Your cat attacks you unprovoked or when you try to pet them

You arms and legs are covered in cratch and bite marks

You’ve tried other products without success

You want a natural, drug-free solution

You’re looking for something easy and safe

You want a peaceful relationship with your cat
Backed By Our
Catisfaction Guarantee

👉 Doesn't work for your cat? Full refund.
Backed By Our
Catisfaction Guarantee

CatCalm Family doesn't work for your cats? Get a full refund!
What Cat Parents Say*
*These are real and unedited statements from our customers.
























What Cat Parents Say*
*These are real and unedited statements
from our customers.
























Clinically Proven. Recommended by Vets.

"In my 15 years as a veterinarian, I've had consistently great experiences with cat pheromones. They're completely natural, mimic cats' own calming signals, and have been clinically tested for over 30 years. I recommend them with a clear conscience because they're both safe and remarkably effective."
Dr. Sarah Mitchell, Veterinarian

Clinically
Proven

Veterinarian
Recommended

Safe for Humans
and Pets

No Side
Effects
Clinically Proven.
Recommended by Vets.

"In my 15 years as a veterinarian, I've had consistently great experiences with cat pheromones. They're completely natural, mimic cats' own calming signals, and have been clinically tested for over 30 years. I recommend them with a clear conscience because they're both safe and remarkably effective."
Dr. Sarah Mitchell, Veterinarian

Clinically
Proven

Veterinarian
Recommended

Safe for Humans
and Pets

No Side
Effects
Common Questions Answered
Safety
Does CatCalm smell?
No, not at all. CatCalm is odorless to humans and doesn't affect any animals. It doesn't use any scents, perfumes, or essential oils. Cats don't really smell it. They rather feel it.
Does CatCalm affect my dog (or other pets)?
No. The pheromones used in CatCalm are just organic molecules. They don't mean anything to your dog, other pets, or humans. Only cats' brains are wired in a way to react to these molecules.
Is CatCalm safe for humans?
Yes. The pheromones used in CatCalm are species specific, and humans lack the necessary organs to even detect them. They have no meaning to humans or other animals.
Does CatCalm have side effects?
No. All ingredients used in CatCalm are absolutely safe. They don't sedate your cats and are drug free. You can't overdose.
Can I accidentally overdose CatCalm?
No. CatCalm is completely safe and cannot be overdosed.
Is CatCalm flammable?
No. CatCalm is not flammable and does not contain flammable ingredients.
Is it safe for my cat with asthma?
Yes. CatCalm does not contain any ingredients that are harmful to cats with asthma. We still recommend asking your vet if you want to be sure.
What is inside?
CatCalm Pure contains:
CAP and F4 pheromones, Dipropylene Glycol, Deionized Water, Hydrogenated Castor Oil, Curcumin
Can I use it for kittens?
Yes. CatCalm is not age-specific. You can use it for cats of all ages.
How To Use
How long does one jar last?
Each jar lasts 30+ days of continuous calming effect. The pheromones are released slowly and evenly — no plug, no drop in effectiveness over time. The gel beads will shrink over time. When they are completely dried out, all pheromones have been released and the jar needs to be replaced.
How many jars do I need for my home?
Use CatCalm in each room your cats spend time in. Each jar covers up to 215 ft² (20 m²). For larger rooms, place multiple jars to ensure full coverage and consistent results — more coverage means better results.
When will I see results?
Most customers notice the first signs of improvement within 3 days — like less hissing, more tolerance, or fewer standoffs. By week one, the difference is usually clear. For long-term harmony, we recommend continuous use.
What is the best place to put CatCalm?
Place the jars in all rooms your cats spend time in. Near their beds, food bowls, or favorite spots. You can put it on a shelf, table, or even on the floor. No outlet needed.
Avoid placing it near heat sources or direct sunlight, as that may cause faster evaporation.
Can I use CatCalm with other calming products or medications?
Yes. CatCalm is drug-free and non-reactive, so it’s safe to use alongside other calming products or medications. It works independently by releasing natural pheromones into the air — no interference, no interaction.
What if it doesn’t work for my cats?
If you don’t see results within 90 days, you’re covered by our money-back guarantee — no questions asked, no returns required.
We’re confident it works for 97% of cats, and we want you to feel 100% confident trying it.
Common Questions Answered
Safety
Does CatCalm smell?
No, not at all. CatCalm is odorless to humans and doesn't affect any animals. It doesn't use any scents, perfumes, or essential oils. Cats don't really smell it. They rather feel it.
Does CatCalm affect my dog (or other pets)?
No. The pheromones used in CatCalm are just organic molecules. They don't mean anything to your dog, other pets, or humans. Only cats' brains are wired in a way to react to these molecules.
Is CatCalm safe for humans?
Yes. The pheromones used in CatCalm are species specific, and humans lack the necessary organs to even detect them. They have no meaning to humans or other animals.
Does CatCalm have side effects?
No. All ingredients used in CatCalm are absolutely safe. They don't sedate your cats and are drug free. You can't overdose.
Can I accidentally overdose CatCalm?
No. CatCalm is completely safe and cannot be overdosed.
Is CatCalm flammable?
No. CatCalm is not flammable and does not contain flammable ingredients.
Is it safe for my cat with asthma?
Yes. CatCalm does not contain any ingredients that are harmful to cats with asthma. We still recommend asking your vet if you want to be sure.
What is inside?
CatCalm Pure contains:
CAP and F4 pheromones, Dipropylene Glycol, Deionized Water, Hydrogenated Castor Oil, Curcumin
Can I use it for kittens?
Yes. CatCalm is not age-specific. You can use it for cats of all ages.
How To Use
How long does one jar last?
Each jar lasts 30+ days of continuous calming effect. The pheromones are released slowly and evenly — no plug, no drop in effectiveness over time. The gel beads will shrink over time. When they are completely dried out, all pheromones have been released and the jar needs to be replaced.
How many jars do I need for my home?
Use CatCalm in each room your cats spend time in. Each jar covers up to 215 ft² (20 m²). For larger rooms, place multiple jars to ensure full coverage and consistent results — more coverage means better results.
When will I see results?
Most customers notice the first signs of improvement within 3 days — like less hissing, more tolerance, or fewer standoffs. By week one, the difference is usually clear. For long-term harmony, we recommend continuous use.
What is the best place to put CatCalm?
Place the jars in all rooms your cats spend time in. Near their beds, food bowls, or favorite spots. You can put it on a shelf, table, or even on the floor. No outlet needed.
Avoid placing it near heat sources or direct sunlight, as that may cause faster evaporation.
Can I use CatCalm with other calming products or medications?
Yes. CatCalm is drug-free and non-reactive, so it’s safe to use alongside other calming products or medications. It works independently by releasing natural pheromones into the air — no interference, no interaction.
What if it doesn’t work for my cats?
If you don’t see results within 90 days, you’re covered by our money-back guarantee — no questions asked, no returns required.
We’re confident it works for 97% of cats, and we want you to feel 100% confident trying it.






